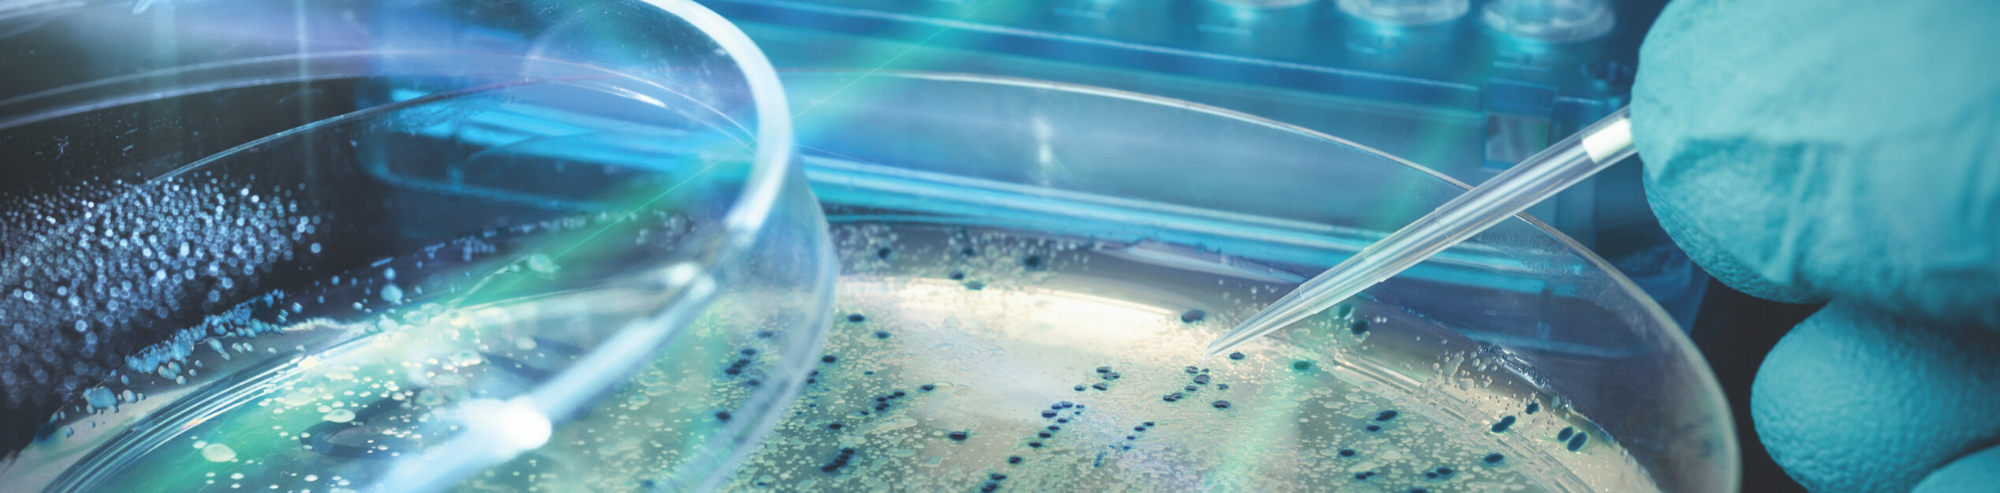
Introducción a Células Competentes

Molecular Cloning: A Detailed Introduction
Molecular cloning is a primary procedure in contemporary biosciences. This involves introducing a specific piece of DNA (most often a gene) into a cell where...


Molecular cloning is a primary procedure in contemporary biosciences. This involves introducing a specific piece of DNA (most often a gene) into a cell where...
Este artículo ofrece una introducción detallada a las células competentes junto con ilustraciones útiles. Aprende qué son las células competentes, cuál es la diferencia entre...

Butterfly patterning and coloring comes from a few specific genes; however, it’s not just the genes but also a complex network of regulatory sequences and...

unque hayas utilizado IPTG para tus experimentos, es posible que no estés familiarizado con el mecanismo de inducción de IPTG. Este artículo proporciona una revisión...

En la larga historia de la biología, ¡ha habido tantos descubrimientos asombrosos! Los avances en los orígenes de la vida, los mecanismos de la vida,...

La investigación genética se ha disparado en las últimas décadas con tecnologías emergentes, avances en la secuenciación y el avance de la sofisticación de la...

What is Agrobacterium? Agrobacterium is a naturally occurring soil bacterium with the unique ability to transfer part of its DNA into plant cells. It is...

a electroforesis en gel de agarosa es un método de biología molecular para analizar y separar fragmentos de ADN basados en su tamaño. Cuando usas...

Qué es TCEP? Tris (2-carboxietil) fosfina o por su nombre en inglés más conocido Tris (2-carboxyethyl) phosphine (TCEP) es un agente reductor usado en investigación...

Plant genetic transformation (PGT) is a process where DNA is introduced into plant cells, tissues, or organs using molecular and cellular biology methods. Through plant...

La Albúmina de Suero Bovino (ASB) es universal en el laboratorio, ya que tiene usos en la técnica de Western blot, en cultivos celulares, en...

Desde muy temprano en los años de 1970, las enzimas de restricción han sido una parte importante en la clonación y muchas otras aplicaciones, incluyendo...
